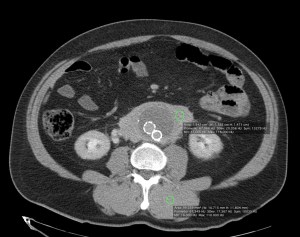
La masa es isodensa con respecto al músculo. 67 UH aprox.
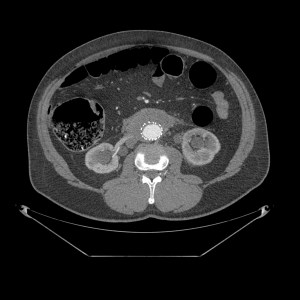
Corte a nivel renal. Protesis aórtica sin alteaciones.
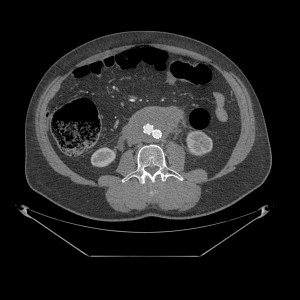
Corte a nivel bifurcación iliaca. Prótesis aórtica sin alteraciones.

CASO 1:
Paciente de 75 años de edad que acude a urgencias por cuadro de abdomen agudo. AP: Operado de hernia inguinal hace 48 horas. Alteración de las constantes vitales, se sospecha perforación por lo cual se demanda TAC de abdomen.
Veamos los hallazgos en una TAC con y sin contraste:






Decimos masa en este caso, aunque se podría pensar que es un sangrado de aneurisma. ¿Por qué no es esta última opción? Observar en primer lugar las paredes de la aorta delimitada por calcio, es decir, sus paredes están calcificadas. Para que pudiésemos hablar de aneurisma, nuestra masa debería tener el calcio en su perifería, Signo del calcio tangencial, y esto no ocurre. La aorta está calcificada y no está sangrando, lo cual se ve reforzado por el hecho de que la masa rodea de una manera uniforme y armoniosa la aorta; un sangrado no sería tan regular, no rodearía de una manera tan perfecta la arteria y además habría predominio de sangrado hacia algún lado de nuestra aorta. Solución: Estamos ante un linfoma.
CASO 2:
Paciente con aneurisma de aorta con dolor abdominal difuso y bilateral. Sin otros hallazgos clínicos y ni analíticos. Constantes vitales estables.

El TC abdominal en fase portal y excretora evidencian una masa que compromete ambos uréteres, más acentuada a la izquierda, produce hidronefrosis bilateral, hallazgo muy infrecuente en el linfoma. Además es isodenso con respecto al músculo, rodea la aorta por la parte anterior, no la desplaza hacia adelante y está en situación infrarrenal predominantemente. No hay adenopatías. Solución: estamos ante una Fibrosis Retroperitoneal.
SIGNO DE LA AORTA FLOTANTE (Floating aorta sign):
Representa el crecimiento y coalescencia de conglomerados adenopáticos que desplazan la aorta lumbar hacia adelante, despegándola de la columna. Este signo lo producen algunos tumores, en especial el Linfoma. Así, da la impresión de que la aorta está «flotando» inmersa en una masa de partes blandas retroperitoneal que se ha formado por el crecimiento de las adenopatías de las cadenas periaórticas, pericavas e interaortocavas, las cuales finalmente se han unido. Otro signo muy útil es el signo del Sandwich, donde se observa, en un TC con contraste, como la masa envuelve los vasos y la grasa del mesenterio.


Aparte del linfoma, en las otras etiologías, puede no existir el desplazamiento de la aorta lumbar (algunas metástasis, fibrosis), puede haber menos coalescencia de los conglomerados adenopáticos (TBC, micobacaterias atípicas), puede observarse áreas hipoatenuadas en su interior de necrosis (leiomiosarcoma) o con densidad grasa (liposarcoma) o las adenopatías pueden tener un realce ávido de contraste (E. de Castleman). En la fibrosis retroperitoneal la atenuación con contraste es más uniforme, la localización suele ser infrarrenal, sin desplazamiento anterior de aorta y con afectación de uréteres. Las posibilidades son numerosas y cada una tiene sus características.
Diagnóstico diferencial:
1- Linfoma, el más frecuente.
2- Metástasis Retroperitoneal ( Ca. de testículo, de cérvix, de mama).
3- Otras: Fibrosis retroperitoneal, Adenopatías Infecciosas (TBC, micobacaterias atípicas), Enf de Castleman (Displasia angiofolicular), Neoplasias primarias malignas o benignas, Tumor neuroendocrino.
Bibliografía.
http://www.scielo.cl/scielo.php?script=sci_arttext&pid=S0717-93082010000300009
http://radiopaedia.org/articles/floating-aorta-sign
Deja un comentario